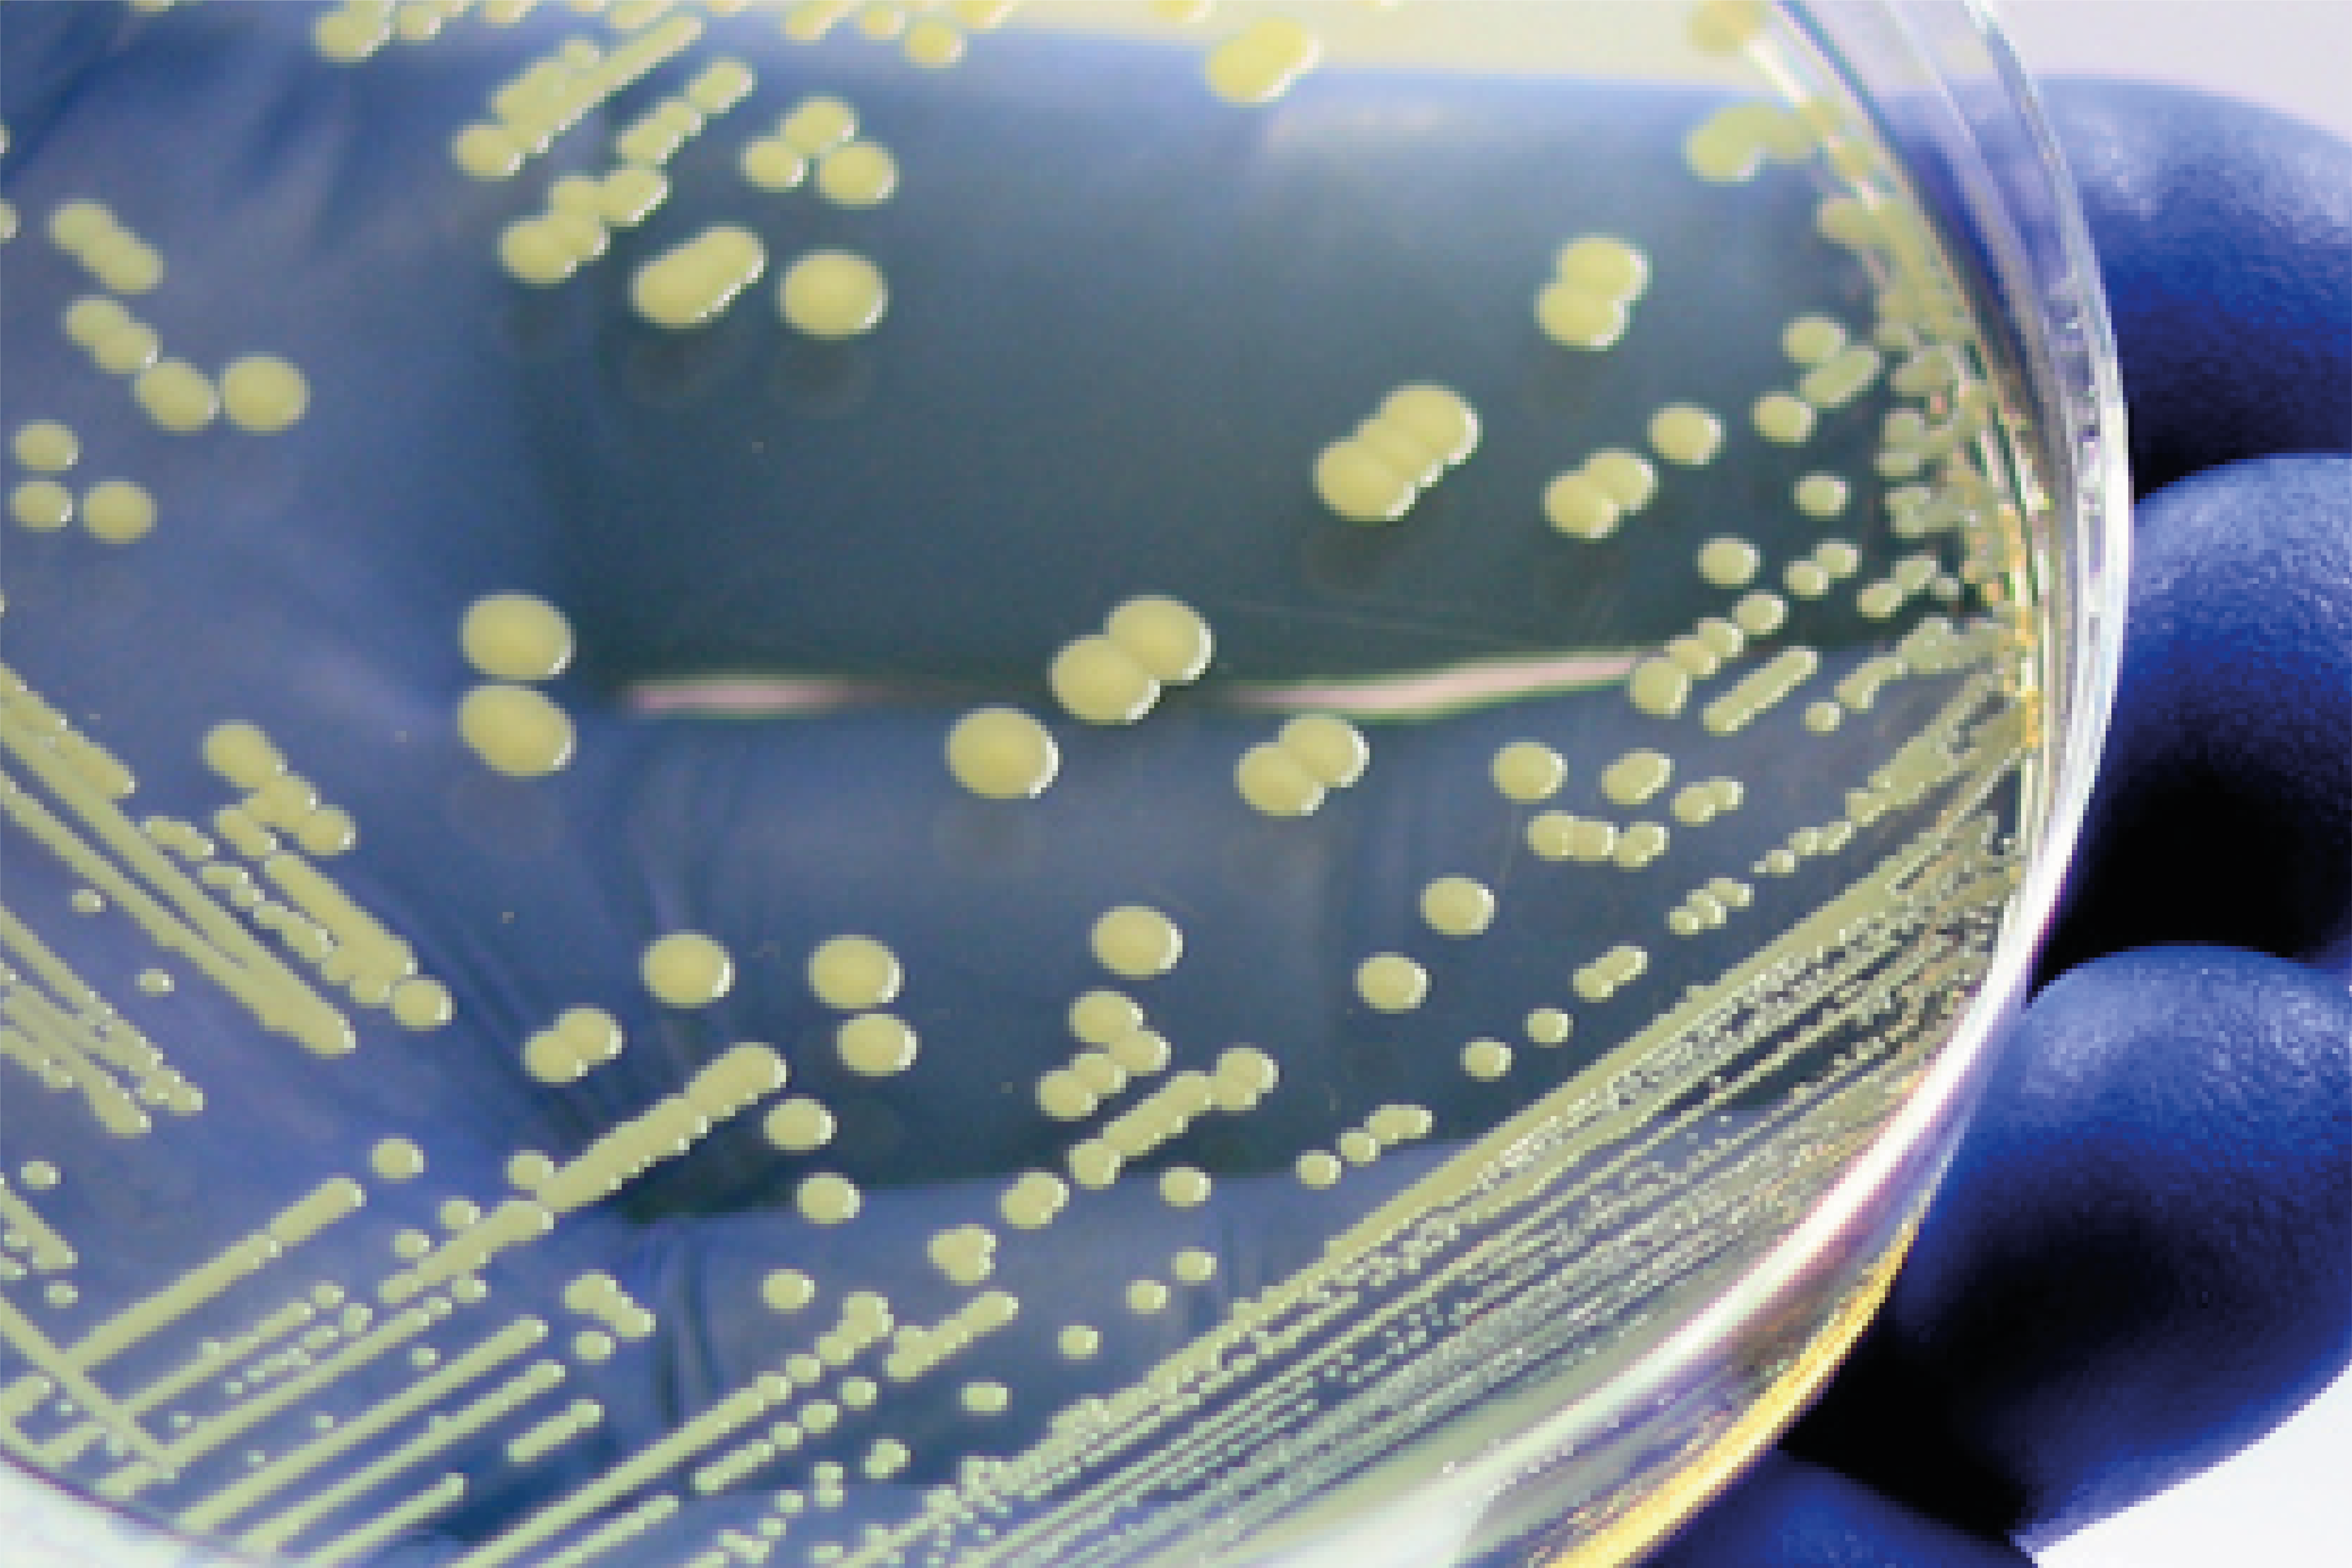

Assurez la maîtrise du risque infectieux de vos dispositifs et produits grâce à des essais sur mesure. Bénéficiez d'un accompagnement de la conception à la conformité réglementaire, avec un soutien scientifique et des méthodes innovantes adaptées à vos besoins.
Des prestations adaptées à vos besoins

Validation LDE
Laveur Désinfecteur d'Endoscope

Validation ESET
Validation Enceinte de Stockage d'Endoscopes Thermosensibles

Validation LDI
Laveur Désinfecteur d'Instruments
En savoir plus
Ils nous ont fait confiance !
Et vous, quand nous rejoignez-vous ?